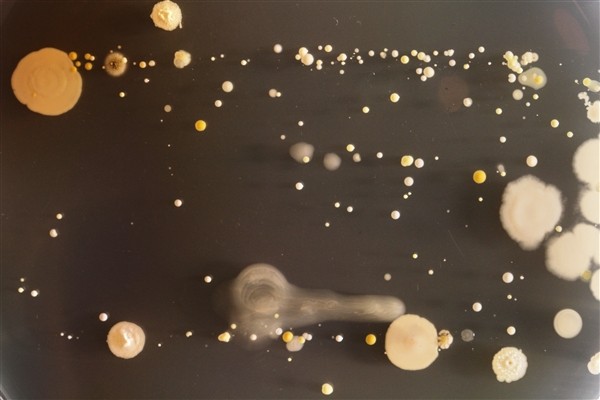
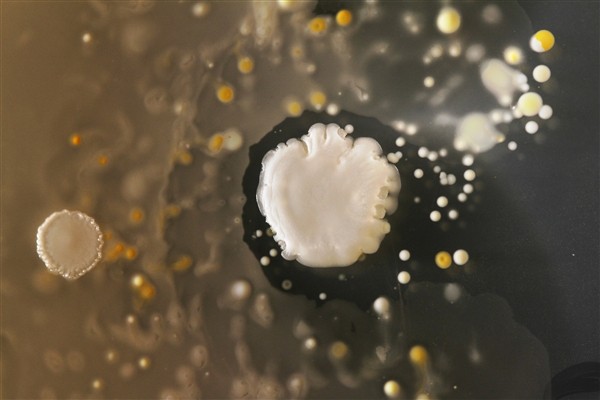

亲眼看一看手机上的细菌
发布时间:2021-04-11 00:10:06
发布时间:2021-04-11 00:10:06

手机暗藏大量细菌,这已经不是什么新闻,不过当你近距离观察这些细菌时,或许能重新认识一下手机。英国萨里大学分子生物学的一群本科生们就更直观地看到了手机上细菌到底是什么样的,他们的导师将手机上的细菌提取出来,放到培养皿中静待了数日。通过这个简单的实验,你能清晰地看到手机上的大量细菌,虽然其中大部分是无害的,不过也有携带疾病的细菌,如金黄色葡萄球菌。

手机暗藏大量细菌,这已经不是什么新闻,不过当你近距离观察这些细菌时,或许能重新认识一下手机。英国萨里大学分子生物学的一群本科生们就更直观地看到了手机上细菌到底是什么样的,他们的导师将手机上的细菌提取出来,放到培养皿中静待了数日。通过这个简单的实验,你能清晰地看到手机上的大量细菌,虽然其中大部分是无害的,不过也有携带疾病的细菌,如金黄色葡萄球菌。

手机暗藏大量细菌,这已经不是什么新闻,不过当你近距离观察这些细菌时,或许能重新认识一下手机。英国萨里大学分子生物学的一群本科生们就更直观地看到了手机上细菌到底是什么样的,他们的导师将手机上的细菌提取出来,放到培养皿中静待了数日。通过这个简单的实验,你能清晰地看到手机上的大量细菌,虽然其中大部分是无害的,不过也有携带疾病的细菌,如金黄色葡萄球菌。

手机暗藏大量细菌,这已经不是什么新闻,不过当你近距离观察这些细菌时,或许能重新认识一下手机。英国萨里大学分子生物学的一群本科生们就更直观地看到了手机上细菌到底是什么样的,他们的导师将手机上的细菌提取出来,放到培养皿中静待了数日。通过这个简单的实验,你能清晰地看到手机上的大量细菌,虽然其中大部分是无害的,不过也有携带疾病的细菌,如金黄色葡萄球菌。

手机暗藏大量细菌,这已经不是什么新闻,不过当你近距离观察这些细菌时,或许能重新认识一下手机。英国萨里大学分子生物学的一群本科生们就更直观地看到了手机上细菌到底是什么样的,他们的导师将手机上的细菌提取出来,放到培养皿中静待了数日。通过这个简单的实验,你能清晰地看到手机上的大量细菌,虽然其中大部分是无害的,不过也有携带疾病的细菌,如金黄色葡萄球菌。

手机暗藏大量细菌,这已经不是什么新闻,不过当你近距离观察这些细菌时,或许能重新认识一下手机。英国萨里大学分子生物学的一群本科生们就更直观地看到了手机上细菌到底是什么样的,他们的导师将手机上的细菌提取出来,放到培养皿中静待了数日。通过这个简单的实验,你能清晰地看到手机上的大量细菌,虽然其中大部分是无害的,不过也有携带疾病的细菌,如金黄色葡萄球菌。
手机暗藏大量细菌,这已经不是什么新闻,不过当你近距离观察这些细菌时,或许能重新认识一下手机。英国萨里大学分子生物学的一群本科生们就更直观地看到了手机上细菌到底是什么样的,他们的导师将手机上的细菌提取出来,放到培养皿中静待了数日。通过这个简单的实验,你能清晰地看到手机上的大量细菌,虽然其中大部分是无害的,不过也有携带疾病的细菌,如金黄色葡萄球菌。
上一篇 : 眼中的寄生虫
下一篇 : 危险之美:显微镜下病毒彩显图